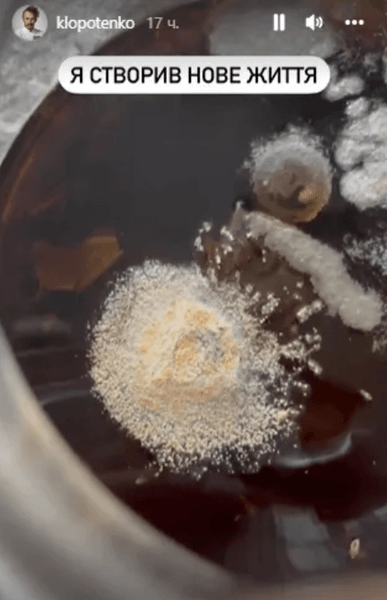

Євген Клопотенко поділився враженнями від Києва після довгої відсутності

Шеф-кухар повернувся додому до столиці України вперше від початку повномасштабної війни.
Відомий український шеф-кухар Євген Клопотенко від початку повномасштабної війни виїхав зі столиці. Кулінарний експерт довгий час подорожував Європою, розповідаючи правду про війну, яку розв'язала Росія, і брав участь у благодійних акціях. Нещодавно він повернувся додому після більш ніж трьох місяців відсутності й жартівливо показав своїм підписникам в Instagram-stories, що виявив у себе у квартирі.
Як і багато хто з тих, хто залишав свої будинки в перші дні війни, сподіваючись повернутися в найближчі кілька днів або максимум тижнів, Клопотенко забув прибрати деякі продукти, що швидко псуються. За три місяці відсутності чай, залишений на столі, покрився цвіллю, а банан зіпсувався і засох.
"Приїхав до Києва. Зараз будуть важливі новини з мого будинку. Минулого разу забув чай викинути. Подивіться, яка ідеальна пліснява. Як можна її не любити", — сказав Клопотенко, показавши на знімку заварник із недопитим чаєм, у якому виріс грибок.
Шеф-кухар розповів підписникам, що досі не прибрав новорічної ялинки, яку планує не розбирати "до Перемоги". А також поділився своїми враженнями від Києва після тривалої відсутності.
"Така красива столиця" — підписав шеф-кухар сторіс з коротким відео пейзажу неймовірної краси.
Фокус раніше писав, що в останні місяці багато знаменитостей, які вимушено виїхали зі столиці України в інші безпечніші регіони або за кордон, почали повертатися додому. Серед тих, хто повернувся, телеведуча Катя Осадча. Нещодавно вона розповіла, як зустріла війну в Києві 24 лютого.
Також Фокус розповідав, що після тривалих гастролей у США до України повернулася співачка KAZKA. Її будинок під Гостомелем під час окупації пограбували російські військові. Знаменитість розповіла, що окупанти винесли майже всю техніку та цінні речі, залишивши страшний безлад. Вони забрали навіть тридцятикілограмову колонку та намагалися вкрасти мікрофон, але загубили його по дорозі.